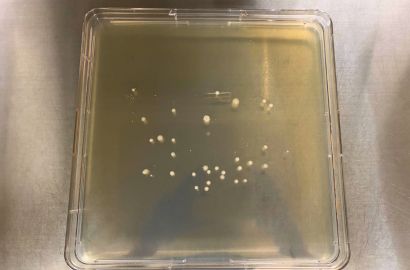
外勤男性1日着用17時間後外側
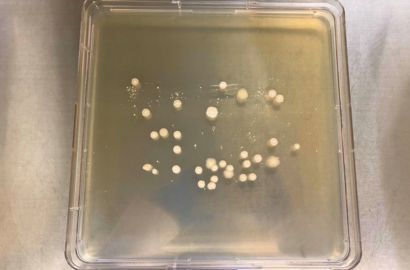
外勤男性1日着用24時間後外側
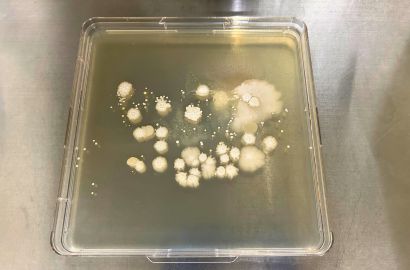
外勤男性1日着用40時間後外側
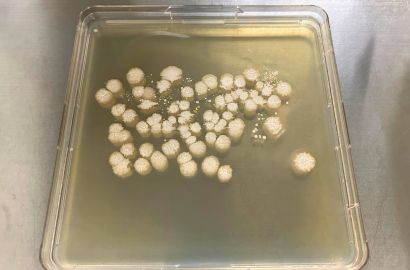
外勤男性1日着用40時間後内側
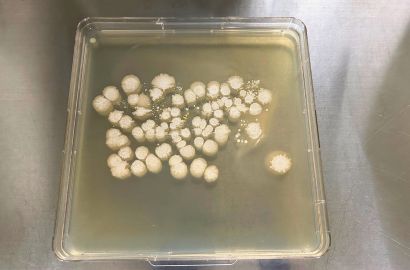
外勤男性1日着用48時間後外側
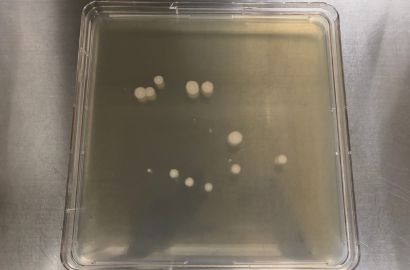
内勤女性1日着用17時間後外側
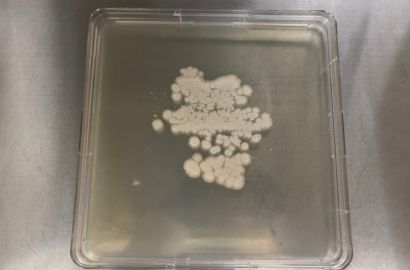
内勤女性1日着用24時間後内側
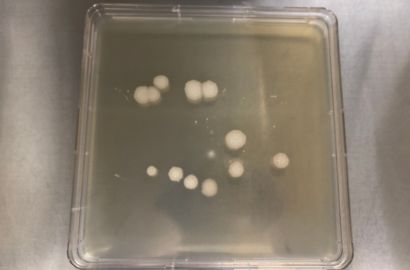
内勤女性1日着用24時間後外側
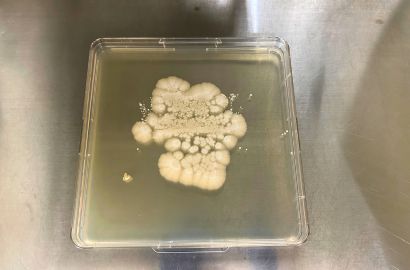
内勤女性1日着用40時間後内側
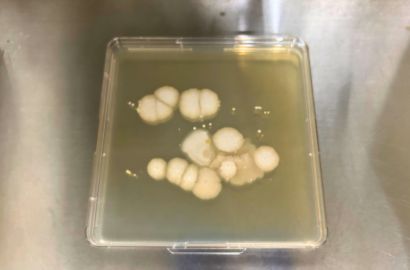
内勤女性1日着用40時間後外側
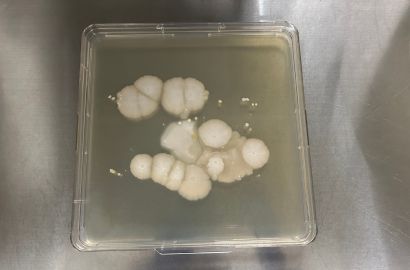
内勤女性1日着用48時間後外側
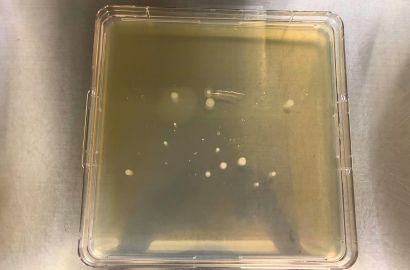
外勤男性2日着用17時間外側
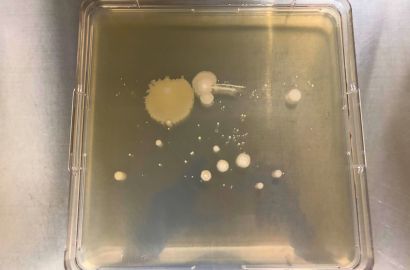
外勤男性2日着用24時間外側
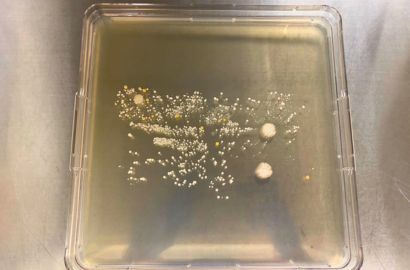
外勤男性2日着用40時間内側
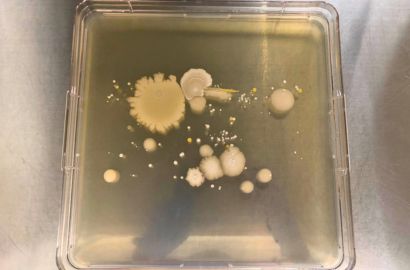
外勤男性2日着用40時間外側
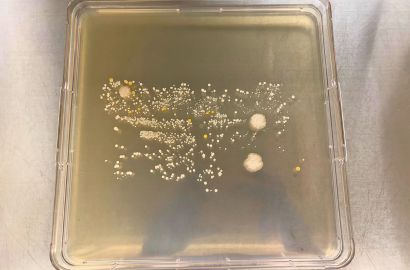
外勤男性2日着用48時間内側
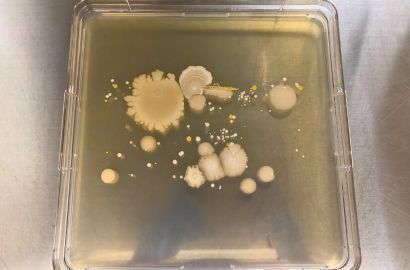
外勤男性2日着用48時間外側
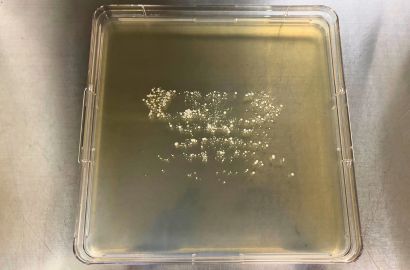
内勤女性2日着用40時間内側
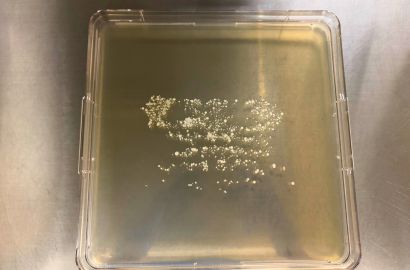
内勤女性2日着用48時間内側

マスクは雑菌だらけ?新型コロナ(ニンバス)流行で再びマスク生活?着けっぱなしの不織布のマスクは安全か
新型コロナウイルスが収束し、数年前と比べてマスクを着用する人が少なくなってきました。一方で、コロナ渦でのマスク着用の習慣化や職場での着用義務化などにより、今でも1日中マスクを着用される方も多いのではないでしょうか。
また、着けっぱなしの不織布のマスクは衛生的に安全なのか?それとも汚いのか?と疑問に思っている方もいるのではないでしょうか。
この記事では、マスクの内側と外側の雑菌環境について詳しく解説します。
目次
唾液や汗がマスクに付着すると、雑菌の栄養源となり、マスク内で繁殖が加速します。
マスクを着用することで、私たちの呼吸や会話によって湿気が生じます。
この湿気は、マスク内の温度を上昇させ、雑菌が繁殖しやすい環境を作り出します。
特に、唾液や汗がマスクに付着すると、雑菌の栄養源となり、繁殖が加速します。
また、マスクの素材によっても雑菌の繁殖速度が異なるため、選び方が重要です。
このように、マスク内の環境は非常にデリケートであり、注意が必要です。
マスクをつけっぱなしにしたら雑菌はどのくらいなのかを検証!
今回、長時間使用したマスクについて雑菌が増えるのかどうかを検証しました。
| 検証内容 | 1日着用したマスク、2日連続着用したマスクの内側と外側の菌数を測定します。 |
|---|---|
| 対象者 | 内勤の女性と外勤の男性の各1名 |
こちらで指定した時間で平日に普段通り生活してもらいました。
【画像あり】マスクの雑菌が増えるまで
培養スタートから17時間後、24時間後、40時間後、48時間後に雑菌が増えているかどうかを確認し、増えるまでの過程を撮影しました。
1日着用した場合
表1 外勤男性の場合
| 外勤男性 | ||
|---|---|---|
| 内側 | 外側 | |
| 培養スタート |  |  |
| 17時間後 |  | |
| 24時間後 |  | |
| 40時間後 | | |
| 48時間後 |  | |
表2 内勤女性の場合
| 内勤女性 | ||
|---|---|---|
| 内側 | 外側 | |
| 培養スタート |  |  |
| 17時間後 |  | |
| 24時間後 | | |
| 40時間後 | | |
| 48時間後 |  | |
2日着用した場合
表3 外勤男性の場合
| 外勤男性 | ||
|---|---|---|
| 内側 | 外側 | |
| 培養スタート |  |  |
| 17時間後 |  | |
| 24時間後 |  | |
| 40時間後 | | |
| 48時間後 | | |
表4 内勤女性の場合
| 内勤女性 | ||
|---|---|---|
| 内側 | 外側 | |
| 培養スタート |  |  |
| 17時間後 |  |  |
| 24時間後 |  |  |
| 40時間後 | |  |
| 48時間後 | |  |
専門家が解説!マスクの内側と外側ではどんな菌が検出されたの?
1日着用した内勤女性では枯草菌(納豆菌)が多く見られました。こちらについて確認したところ検証日の朝に納豆ごはんを食べてきましたとのことでした。
2日着用した外勤男性では黄色ブドウ球菌が見られました。黄色ブドウ球菌は食中毒の原因となる菌になります。
今回の菌数だと問題ありませんが菌数が増えた場合は食中毒になる可能性があります。
マスクの内側と外側で検出された菌について、1日着用と2日着用で主に表皮ブドウ球菌や枯草菌などが検出されました。
表皮ブドウ球菌は人の肌や鼻の中にいる一般的には無害な常在菌です。免疫力が低下している時など稀に感染を引き起こすことがあります。
枯草菌は、納豆菌とも言われ、有用な菌として発酵食品などに利用されています。
また、食中毒を引き起こすセレウス菌と黄色ブドウ球菌も検出されました。
1日着用した場合に検出された菌種
| 外勤男性 | 内勤女性 | ||
|---|---|---|---|
| 内側 | 外側 | 内側 | 外側 |
| ・バチルス菌 ・黄色ブドウ球菌 | ・バチルス菌 ・ブドウ球菌 | ・バチルス菌 ・ブドウ球菌 | ・バチルス菌 ・ブドウ球菌 |
1日着用した場合に検出された菌数
| 外勤男性 | 内勤女性 | ||
|---|---|---|---|
| 内側 | 外側 | 内側 | 外側 |
| 262コロニー | 155コロニー | 456コロニー | 44コロニー |
※コロニーとは、微生物の数を表す単位です。
2日着用した場合に検出された菌種
| 外勤男性 | 内勤女性 | ||
|---|---|---|---|
| 内側 | 外側 | 内側 | 外側 |
| ・バチルス菌 ・黄色ブドウ球菌 ・ブドウ球菌 | ・セレウス菌 ・黄色ブドウ球菌 ・ブドウ球菌 | ・ブドウ球菌 | ・バチルス菌 |
2日着用した場合に検出された菌数
| 外勤男性 | 内勤女性 | ||
|---|---|---|---|
| 内側 | 外側 | 内側 | 外側 |
| 1,200コロニー | 130コロニー | 930コロニー | 101コロニー |
※コロニーとは、微生物の数を表す単位です。
まとめ:マスクは毎日交換であれば安全!
今回の結果から1日着用と2日着用で菌数に差が見られました。
気温が高く汗をかきやすい今の時期は、マスクの内側の温度や湿度も高くなり、菌が繁殖しやすい環境になります。
基本的にマスクは毎日交換し、一時的に外す場合はマスクケースなどを使用して清潔に保管するようにしましょう!
